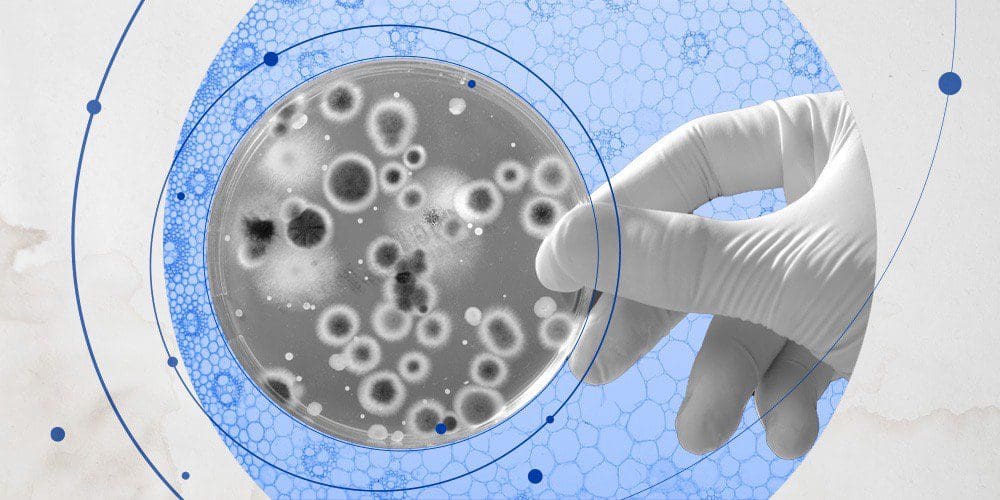
Photo illustration of petri dish.

By Steve McCann | February 27, 2023
It’s long been said Canada doesn’t have an innovation problem; it has an adoption problem. The same is true when it comes to our country’s therapeutics and life sciences sector. Canada has been an academic biotech powerhouse for decades, but many health entrepreneurs have struggled to commercialize their solutions here at home, a dangerous gap made all too clear during the pandemic.
Take, for instance, the case of Derrick Rossi, the molecular biologist from Scarborough whose work on stem cell therapeutics at the University of Toronto was showing great promise. He struggled, however, to find the infrastructure needed to put it into commercial production. So instead, Rossi went to the U.S. where he’d go on to co-found Moderna.
Of the many lessons learned from COVID-19, the pandemic underscored Canada’s need to create a network that not only supports medical research breakthroughs, but also helps potentially life-saving innovations scale from initial concept to commercialization.
MaRS has teamed up with adMare BioInnovations to create the MaRS-adMare Therapeutics (Tx) Accelerator to provide that much-needed boost. Building on the success of adMare’s National Accelerator with Regional Partners that has established hubs in Montreal and Vancouver, this program focuses on early-stage biotherapeutic ventures that have the potential to make a significant market impact.
Participating ventures are given access to key resources: scientific and regulatory guidance, business development and IP strategy coaching, personalized training and team building, access to C-suite executives, industry partners and investors, as well as financial support to achieve milestones. Ventures working out of the MaRS Centre are given access to state-of-the-art wet labs — a game changer when it comes to putting medical breakthroughs to the test.
“This is a generational moment. Truly in our careers and in our lifetimes, we will never see a moment again where everything has come together and presented us with a challenge to finally build a sustainable life sciences industry in this country,” said Gord McCauley, president and CEO of adMare BioInnovations.
There’s a pressing need to get the gears in motion now so that we can start to see the effects of this new partnership in the coming years.
“There is an urgency that needs to be brought to bear for these Canadian companies because while they’re experimenting, so are scientists in Boston or Philadelphia or the Bay Area,” says Amol Deshpande, who is spearheading the Therapeutics Accelerator program for MaRS. “Knowledge and resources sit in very diverse ecosystems, so this brings all the elements early-stage life sciences companies need under one roof.”
Applications are now open, and early-stage companies in a variety of specialties are encouraged to apply. This includes therapeutics ventures that work with disease indicators and categories like immunology, neurology, metabolomics, small molecules, biologics, RNA and cell therapy. Early-stage companies that harness AI and machine learning to support drug therapeutics and discoveries, as well as ventures that develop enabling platforms like drug screening, discovery and delivery are also encouraged to apply.
The applications MaRS receives today could better prepare our country for the next public health emergency, and help ensure Canadian talent not only stays here, but also helps to bring game-changing therapeutics to the world stage, says Deshpande.
“By building a stronger ecosystem, we will be better prepared for the next crisis,” he says. “And from an economic standpoint, it’s about upskilling the workforce and talent we have to a higher level. This will allow us to punch above our weight from a national perspective.”
Applications for the first cohort of the MaRS-adMare Therapeutics Accelerator closes in March. Find out more here.
Photo illustrations: The Workhouse